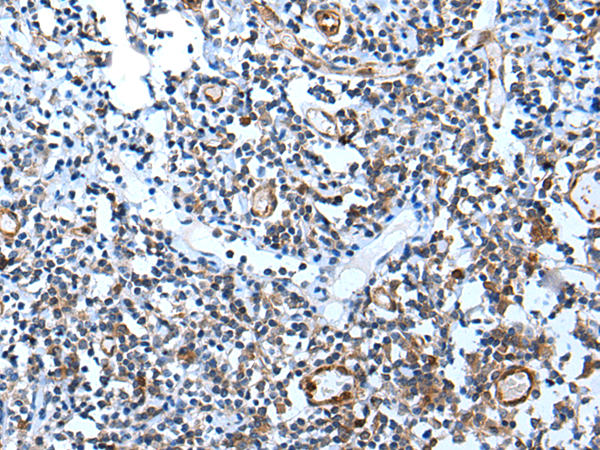

|
Background: |
USP37 (ubiquitin specific peptidase 37) is a 979 amino acid protein that contains three UIM (ubiquitin-interacting motif) repeats and belongs to thepeptidase C19 family. Expressed in prostate and brain tissue, USP37 functions to catalyze the conversion of a ubiquitin C-terminal thioester to a free ubiquitin and a thiol. The gene encoding USP37 maps to human chromosome 2, which houses over 1,400 genes and comprises nearly 8% of the human genome. |
|
Applications: |
ELISA, IHC |
|
Name of antibody: |
USP37 |
|
Immunogen: |
Synthetic peptide of human USP37 |
|
Full name: |
ubiquitin specific peptidase 37 |
|
SwissProt: |
Q86T82 |
|
ELISA Recommended dilution: |
5000-10000 |
|
IHC positive control: |
Human tonsil |
|
IHC Recommend dilution: |
25-100 |

購物車
購物車 幫助
幫助
 021-54845833/15800441009
021-54845833/15800441009
